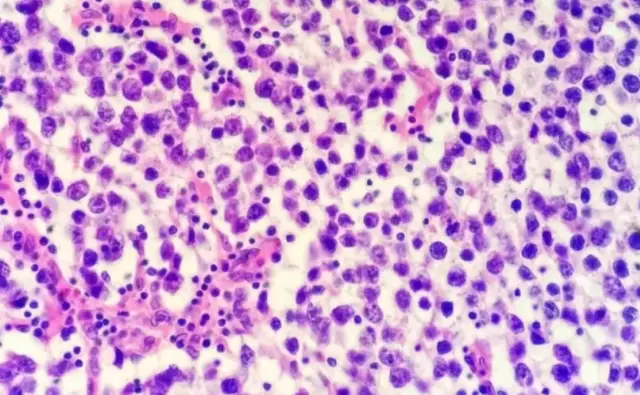

补硒用吃药吗(硒与癌症预防的关系)
王大爷今年67岁,是社区里出了名的“乐天派”。

退休后,他喜欢和老邻居们一起散步、下棋,每天日子过得轻松自在。然而,最近几个月,他的身体状况却悄悄发生了变化。
最近,他经常感到胸闷气短,有时连走上几层楼都喘不过气来。
更奇怪的是,哪怕平时没有剧烈活动,他也常觉得全身乏力,心跳偶尔变得又快又乱。起初,他以为是岁数大了,体力下降,甚至开玩笑说:“人老了,不服不行。”
可有一天,事情变得更严重了。
那天,他和邻居们在社区广场下棋,正准备站起来接水时,突然感到头晕眼花,腿脚发软,胸口像被重物压住一般。
他的棋友老李见状赶紧扶住他,急切地说:“老王,赶紧去医院看看吧,这可不能再拖了!”
在好友地劝说下,王大爷来到了县医院。
经过一系列检查,医生发现他的心脏功能确实有所下降,但问题并非源于冠状动脉或其他明显病变,而是血液中硒含量严重不足。

医生向王大爷解释道,硒是人体必需的微量元素之一,对心脏健康和抗氧化能力有重要作用,缺乏硒可能是他近期症状的主要原因。
王大爷听后满脸疑惑:“硒?这玩意儿不是吃药补补就行了吗?”
医生摇摇头,耐心解释:“关键在于平时的饮食习惯,你日常的精制米面和肉食太单一,没能提供足够的硒。调整饮食,多吃些富含硒的食物,才是改善的长远之道。”
回家后,王大爷开始按照医生的建议改变饮食习惯。
虽然起初有些不适应,但几周后,他的胸闷感明显缓解,爬楼梯也不像以前那么吃力了。
复查时,医生高兴地告诉他,硒水平已经恢复到了正常值。
然而,王大爷依然心存疑问:这小小的硒,真的有这么重要?缺硒对身体的影响到底还有多大?
硒:预防心脏病、抵抗癌症的必需元素
硒是一种人体必需的微量元素,在人体内的含量虽少,却发挥着不可替代的重要作用。

近年来,科学研究不断证实硒在保护心脏健康、增强免疫力以及预防癌症方面的独特作用。
1、保护心脏健康
硒对心脏健康的重要性源于其在抗氧化防御系统中的核心作用。
硒是谷胱甘肽过氧化物酶(GPx)的关键成分,这种酶能清除体内的过量自由基,减少氧化应激对细胞和组织的损害。
氧化应激是导致心血管疾病的重要因素之一,它会引发动脉硬化、血管炎症以及心肌病变。
研究表明,硒水平偏低与心肌病的发生密切相关。
例如,“克山病”就是因缺乏硒而导致的一种地方性心肌病,患者的心脏功能严重受损。
尽管现代饮食结构改善后此病在大范围内减少,但局部地区依然存在低硒饮食引发的心脏问题。
硒还能帮助调节血脂水平,减少低密度脂蛋白(LDL,即“坏胆固醇”)的氧化作用,从而降低动脉粥样硬化的风险。

硒对维持血管弹性、预防心律失常也有显著的保护作用。
2、增强免疫力
硒在免疫系统中的角色同样不可忽视。
作为抗氧化酶的组成部分,硒能有效保护免疫细胞不受自由基损害,从而提高机体对病毒和细菌的抵抗力。
此外,硒还能促进免疫细胞的增殖和分化,增强抗原识别能力,帮助人体更快地清除外来病原体。
对于慢性炎症疾病患者,硒的抗炎作用尤为重要。
低硒状态会加重炎症反应,而适量补硒能够平衡免疫系统,减少炎症因子的释放,减轻相关症状。
3、预防癌症
硒在癌症防治中的作用备受关注,其机制主要体现在以下几个方面:
抑制肿瘤细胞增殖:硒能够有效抑制肿瘤细胞的增殖,并促进癌细胞的凋亡。这种作用机制主要是通过调控细胞周期来实现的。
硒能够干扰癌细胞的DNA合成过程,阻止其在生长周期中完成关键的分裂步骤,使肿瘤细胞无法继续增殖。
同时,硒可以激活癌细胞内部的凋亡机制,例如通过激活细胞内的凋亡蛋白(如Bax)或抑制抗凋亡蛋白(如Bcl-2),诱导癌细胞的自然死亡,从而限制癌症的发展。
增强DNA修复能力:DNA损伤是癌症发生的重要基础之一,而硒在DNA修复过程中起着重要作用。
当体内细胞受到辐射、化学物质或自由基攻击时,DNA链可能出现断裂或突变。
硒能够激活参与DNA修复的酶类和信号通路,例如聚ADP核糖聚合酶(PARP)和p53基因,使受损DNA及时得到修复,从而降低癌变的可能性。通过这种方式,硒能够在基因层面减少癌症的发生率。
强效的抗氧化作用:硒是谷胱甘肽过氧化物酶的核心成分,这种酶是体内最重要的抗氧化剂之一。
硒能够帮助清除体内的自由基和过氧化物,降低氧化应激对细胞的损伤。

自由基和氧化应激被认为是癌症的诱因之一,它们会导致细胞膜、蛋白质以及DNA的结构性破坏。通过减少氧化应激,硒能够在癌症发生的早期阶段阻断病变过程。
抑制肿瘤血管生成:硒在抑制肿瘤血管生成方面也表现出独特的功效。
肿瘤的快速生长依赖于新生血管为其提供营养和氧气,而硒能够通过抑制血管内皮生长因子(VEGF)的表达,阻止肿瘤血管的形成。
这种作用可以有效“饿死”肿瘤,限制其生长和转移能力。此外,硒还能够改变肿瘤微环境,使癌细胞更难以适应,从而进一步抑制癌症的扩散。
流行病学与临床研究的证据:多项流行病学研究表明,低硒水平与多种癌症(如肝癌、肺癌、胃癌、结直肠癌等)的发生率呈显著正相关。
在某些低硒地区,人群的癌症发病率显著高于硒含量正常或偏高的地区。
此外,适量补硒被证明可以降低癌症高危人群的患病风险。临床试验显示,硒补充剂在某些特定癌症(如前列腺癌和肺癌)的预防中效果尤为显著。

缺硒的健康危害
硒是人体维持健康所需的重要元素,但由于饮食结构、地理环境和生活方式的差异,不少人可能面临硒摄入不足的风险。缺硒会引发多种健康问题。
1、心血管疾病
硒水平低与心血管疾病的发病密切相关。
缺硒会导致氧化应激加剧,进而引发动脉粥样硬化、心肌病甚至心力衰竭。硒不足的长期影响可能会加重高血压和高脂血症的病情。
2、免疫功能下降
缺硒会削弱免疫系统的功能,表现为免疫细胞活性降低、抗感染能力减弱,机体更容易感染病毒或细菌。
此外,缺硒还会导致慢性炎症加剧,使免疫系统持续处于高负荷状态,从而加速机体的衰老和退化。

3、癌症风险增加
低硒水平与癌症的发生率呈显著正相关。
硒不足会使细胞更容易受到自由基和毒性物质的侵害,增加基因突变的概率。此外,缺硒还会导致肿瘤抑制基因功能减弱,进一步加大癌症的风险。
4、甲状腺功能异常
硒是甲状腺激素代谢中必需的元素,缺乏硒可能导致甲状腺激素代谢紊乱,表现为甲状腺功能减退或甲状腺炎。
5、其他健康问题
缺硒还可能与男性不育症、骨骼退化、神经系统疾病等有关。硒不足会影响精子的生成与质量,同时增加骨骼和软组织受损的风险。
如何通过饮食补充硒:两类食物的关键作用
硒无法在人体内自行合成,因此必须通过外界补充。饮食是获取硒最安全、最有效的途径,其中以下两类食物是补硒的关键来源。

1、坚果类食物
巴西坚果是补硒的首选食品,被誉为“硒之王”。
一颗巴西坚果含硒量可高达60-80微克,基本能满足成人每日硒的摄入需求。
坚果类食品如核桃、杏仁、腰果等,也含有一定量的硒,同时富含其他营养成分,有助于心血管健康。
需要注意的是,巴西坚果的硒含量较高,过量摄入可能引发硒中毒,每天食用1-2颗即可满足需求。
2、全谷物类食物
全谷物食品如糙米、燕麦、全麦面包等,富含天然硒及其他矿物质。
与精制谷物相比,全谷物中的硒含量更高,同时富含膳食纤维和维生素B族,能促进消化和代谢,有助于整体健康。
此外,地理环境对谷物的硒含量有一定影响。土壤中硒含量丰富的地区,其种植的粮食作物硒含量也更高。因此,选择适当的产地也有助于获取更多硒。

合理补硒的注意事项
尽管硒对健康有诸多益处,但补充硒也需科学合理,避免过量摄入引发副作用:
1、控制摄入量
硒的每日推荐摄入量为成年人55微克,安全摄入上限为400微克。
过量摄入硒可能导致恶心、脱发、指甲脆弱等不良反应,甚至引发神经系统损伤。因此,应优先选择从饮食中摄取硒,避免过度依赖补硒剂。
2、搭配均衡饮食
补硒并不意味着单一摄入某些高硒食物,而是需要与其他营养元素均衡搭配。例如,维生素E与硒协同作用,能进一步增强抗氧化效果。
3、了解自身需求
不同人群对硒的需求量不同,孕妇、哺乳期女性及特定疾病患者可能需要适当增加硒的摄入。在补充硒前,可通过血液检测了解自身硒水平,确保摄入量符合健康需求。

总结
硒,这一微量元素虽然不起眼,却是健康的“大英雄”。
它在保护心脏健康、增强免疫功能和预防癌症中发挥着重要作用。
从抑制肿瘤细胞增殖到清除自由基,从维持免疫平衡到促进DNA修复,硒的作用机制无处不在。硒的摄入不足,会增加多种疾病的风险,尤其是心血管疾病和癌症。
幸运的是,硒的获取并不复杂。
通过多吃富硒食物,如巴西坚果和全谷物,我们可以轻松补充这一“健康元素”。
当然,科学补硒还需要控制摄入量,避免过量带来的副作用。

硒虽微,却意义重大。通过关注饮食细节,合理补充硒,让它成为您日常健康管理的一部分,远离心脏病和癌症的威胁,迈向更健康的生活。
继续阅读
- 暂无推荐
